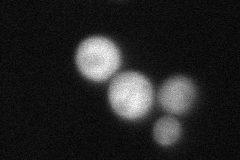
YBL045C
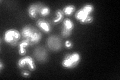
YBL045C

View description
Core subunit of the ubiquinol-cytochrome c reductase complex (bc1 complex), which is a component of the mitochondrial inner membrane electron transport chain
Localization:
Intensity:
Fold change:
Significance:
-
C’ GFP library in SD

mitochondria101.48 -
N' NOP1pr-GFP in SD

mitochondria177.259 -
N' TEF2pr-mCherry in SD

mitochondriaN/A -
N' NATIVEpr-GFP in SD
cytosol,punctate56.7155 -
N' TEF2pr-VC and Cyto-VN in SD

#N/A0 -
C’ GFP library in SD+DTT

mitochondria122.61.2No -
C’ GFP library in SD+H2O2

mitochondria78.390.77No -
C’ GFP library in Starvation Media
mitochondria169.821.67Yes -
C’ GFP library on the background of Pup2-DaMP

mitochondria -
C’ GFP library on the background of CCT mutant

mitochondria84.03760.828005No
